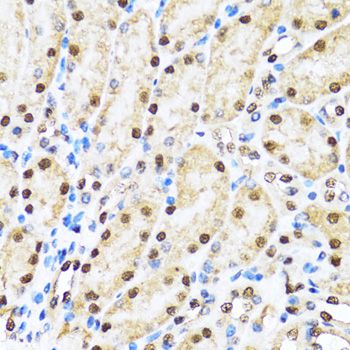

Filters
Clonality
Type
Reactivity
Gene Name
Isotype
Host
Application
Clone
7106 results for " Mouse" - showing 3500-3550
PAFAH1B3, Monoclonal Antibody (Cat# AAA25482)
MAPK8, Polyclonal Antibody (Cat# AAA10635)
MCL1, Polyclonal Antibody (Cat# AAA10630)
RXRA, Polyclonal Antibody (Cat# AAA23431)
LIMK1, Monoclonal Antibody (Cat# AAA25737)
SPRY2, Monoclonal Antibody (Cat# AAA24966)
SWAP70, Monoclonal Antibody (Cat# AAA24973)
GABPA, Monoclonal Antibody (Cat# AAA26509)
PCNA, Monoclonal Antibody (Cat# AAA25487)
2019-03-07, Monoclonal Antibody (Cat# AAA25744)
ADPGK, Polyclonal Antibody (Cat# AAA23436)
GAPDH, Monoclonal Antibody (Cat# AAA26252)
KCNK9, Polyclonal Antibody (Cat# AAA23441)
FKBP4, Monoclonal Antibody (Cat# AAA24212)
MEOX2, Monoclonal Antibody (Cat# AAA25750)
FTL, Monoclonal Antibody (Cat# AAA26011)
SCAI, Monoclonal Antibody (Cat# AAA29859)
CD274 molecule, ELISA Kit (Cat# AAA18340)
GROS1, Monoclonal Antibody (Cat# AAA24228)
NDUFV2, Monoclonal Antibody (Cat# AAA25764)
CDH11, Monoclonal Antibody (Cat# AAA26012)
CELF2, Polyclonal Antibody (Cat# AAA23473)
CDC2, Monoclonal Antibody (Cat# AAA24753)
GEMIN2, Polyclonal Antibody (Cat# AAA10679)
CD58, Monoclonal Antibody (Cat# AAA24751)
CCAR2, Polyclonal Antibody (Cat# AAA28085)
FGL2, Monoclonal Antibody (Cat# AAA14772)
Purified by Protein A affinity chromatography.